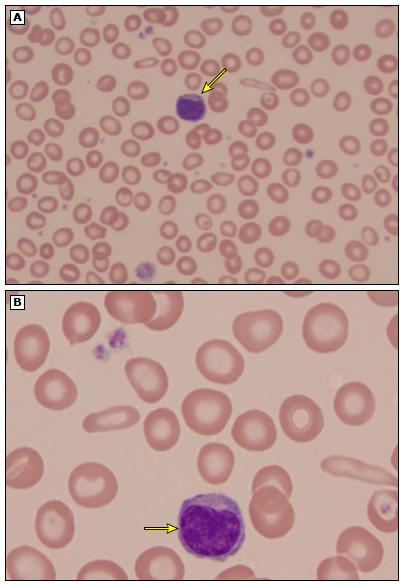

20대
혈액검사에서 빈혈 진단 받고 철분제를 몇 일 복용하고 내원하였습니다.
Hb 9.7
microcytic hypochromic anemia
PBS : anisocytosis, poikilocytosis, tear drop cell




Poikilocytosis : Elliptical forms are common, and elongated pencil (cigar) shaped cells may be seen. Target cells and Teardrop cells may also be present in small numbers. Severe anemia shows ring/pessary cells.
모양 Permutations in red blood cell shape (poikilocytosis)
크기 Divergent population of red cells of different sizes (ie, the presence of anisocytosis)
Causes of microcytic anemia (mean corpuscular volume less than 80 fL)
|
Hereditary disorders |
|
Defects of globin synthesis |
|
Thalassemia syndromes |
|
Thalassemic hemoglobinopathies (eg, hemoglobin [Hb]E, Hb Lepore) |
|
Defects of iron metabolism |
|
Iron refractory iron deficiency anemia (IRIDA)* |
|
Divalent metal transporter (DMT)1 mutations* |
|
Atransferrinemia* |
|
Sideroblastic anemia |
|
Acquired disorders |
|
Iron deficiency anemia |
|
Myelodysplastic syndrome (MDS) with acquired thalassemia* |
|
Sideroblastic anemias due to drugs or toxins (lead poisoning, alcohol, drugs) |
|
Copper deficiency (some cases) |
|
Zinc deficiency |
The two most common causes of microcytosis are shown in red type.
* Very rare cause of microcytosis.
Microcytosis (mean corpuscular volume [MCV] <80 fL) usually reflects a decreased hemoglobin content within the red blood cell (RBC), and is often associated with a parallel reduction in mean corpuscular hemoglobin (MCH), producing a hypochromic appearance on blood smear.
The three most common causes of microcytosis are iron deficiency, thalassemia, and anemia of chronic inflammation. Iron deficiency may be seen in parts of the world where nutrition is inadequate, or in individuals with chronic blood loss, including menstruating women and individuals with gastrointestinal bleeding. Anemia of chronic inflammation (anemia of chronic disease) may be associated with microcytosis and anemia, although normal RBC size is more frequently seen; however, the overall high prevalence of this condition, especially in the developed world, makes it a common cause of microcytosis even though microcytosis is not the most common manifestation. Thalassemia major and thalassemia intermedia are more common in certain parts of the world, but thalassemia trait may be identified as an incidental finding. Iron deficiency and thalassemia are both characterized by decreased hemoglobin production, due to insufficient availability of heme or globin, respectively.
Rare causes of microcytosis include lead poisoning, copper or zinc deficiency, some forms of drug-induced anemia, inherited syndromes of defective iron metabolism, and myelodysplastic syndrome (MDS).
Peripheral blood smear in iron deficiency anemia showing microcytic, hypochromic red blood cells
The same peripheral blood smear from a patient with iron deficiency is shown at two different magnifications. Small (microcytic) red blood cells are shown, many of which have a thin rim of pink hemoglobin (hypochromia). Occasional "pencil"-shaped cells are also present. A small lymphocyte is shown for size comparison (arrow). Normal red blood cells are similar in size to the nucleus of a small lymphocyte (arrow), and central pallor in normal red blood cells should equal approximately one-third of the cell diameter.
Kindly supplied by Dr. German Pihan, Department of Pathology, Beth Israel Deaconess Medical Center, Boston, MA.
Normal peripheral blood smear

High-power view of a normal peripheral blood smear. Several platelets (arrowheads) and a normal lymphocyte (arrow) can also be seen. The red cells are of relatively uniform size and shape. The diameter of the normal red cell should approximate that of the nucleus of the small lymphocyte; central pallor (dashed arrow) should equal one-third of its diameter.
Courtesy of Carola von Kapff, SH (ASCP).
REF. UpToDate 2019.06.28
'혈액내과 > 수혈' 카테고리의 다른 글
| 동결침전제제, 임상적 사용, Cryoprecipitate, clinical uses (0) | 2020.04.25 |
|---|---|
| 혈소판 수혈이 필요한 혈소판 수, Indications for platelet transfusion (0) | 2020.04.25 |
| Warm autoimmune hemolytic anemia (0) | 2019.06.23 |
| Febrile non-hemolytic transfusion reaction(FNHTR), management (0) | 2018.10.28 |
| 면역 수혈 반응 중 두드러기(알러지) 반응, Urticarial (allergic) reactions, immunologic transfusion reactions (0) | 2018.10.28 |